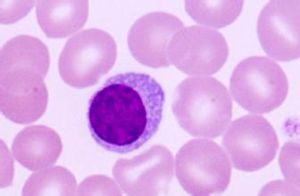
自然殺傷細胞

細胞來源
自然殺傷細胞
自然殺傷細胞由於NK細胞具有部分T細胞分化抗原,如80~90%NK細胞CD2+,20~30%NK細胞CD3+(表達CD3ζ鏈),30%NK細胞CD8+(α/α)和75~90%NK細胞CD38+,而且NK細胞具有IL-2中親和性受體,在IL-2刺激下可發生增殖反應,活化NK細胞可產生IFN-γ,因此一般認為NK細胞與T細胞在發育上關係更為密切。
細胞表型
與T細胞、B細胞相比,NK細胞表面標誌的特異性是相對的。人NK細胞mIg-,部分NK細胞CD2、CD3和CD8陽性,表達IL-2受體β鏈(P75,CD122),CD11b/CD18陽性。常用檢測NK細胞的標記有CD16、CD56、CD57、CD59、CD11b、CD94和LAK-1(見表7-10)。
一種穩定表達在NK和LAK細胞表面的LAK-1分子,120kDa,NK細胞在IL-2條件下培養20天LAK-1仍為陽性,而HNK-1(CD57)和CD16部分消失。LAK的殺傷活性可被抗LAK-1McAb所抑制。
檢測人NK細胞常用的標誌
NK細胞和其它細胞毒效應細胞的表面標誌(%)
活化途徑
 自然殺傷細胞
自然殺傷細胞NK細胞不表達TCR/CD3複合物,但部分NK細胞表達CD3ζ鏈,當用CD16抗體刺激NK細胞活化時,ζ鏈發生酪氨酸磷酸化,引起胞漿內Ca2+濃度升高,IP3水平增加,促進細胞因子合成和ADCC作用。
通過CD2分子
CD2與CD58相互作用或用CD2McAb刺激可活化NK細胞,CD3ζ鏈發生酪氨酸磷酸化。
自然殺傷細胞刺激因子
自然殺傷細胞刺激因子(naturalkillercellstimulatoryfactor,NKSF)對NK細胞有刺激作用。
IL-2、IL-12、IFN-α、TNF-α以及白細胞調節素(leukoregulin,LR)對NK細胞的活化和分化有正調節作用,體外培養時加入上述細胞因子可明顯提高NK的殺傷活性。前列腺素(PG)E1、E2、D2和腎上腺皮質激素等對NK細胞的活性有抑制作用。
NK細胞表面具有IL-2中親和性受體,IL-2誘導NK的殺傷活性約需18~24小時。此外,IL-2還可誘導NK細胞的增殖,一般在刺激後3~4天開始發生增殖,其機理為IL-2可誘導NK細胞表達IL-2Rα鏈,新表達的α鏈與原先細胞表面的β鏈和γ鏈結合形成高親和性受體,在IL-2存在下刺激NK細胞發生增殖。IL-2誘導NK細胞的活性機理尚不清楚,可能與增加細胞粘附分子的表達,提高對NK抵抗靶細胞的殺傷活性有關,還可能增加NK細胞胞漿中的顆粒以及絲氨酸酯酶mRNA的表達,活化和促進殺傷介質的殺傷作用。
細胞功能
自然殺傷活性
由於NK細胞的殺傷活性無MHC限制,不依賴抗體,因此稱為自然殺傷活性。NK細胞胞漿豐富,含有較大的嗜天青顆粒,顆粒的含量與NK細胞的殺傷活性呈正相關。NK細胞作用於靶細胞後殺傷作用出現早,在體外1小時、體內4小時即可見到殺傷效應。NK細胞的靶細胞主要有某些腫瘤細胞(包括部分細胞系)、病毒感染細胞、某些自身組織細胞(如血細胞)、寄生蟲等,因此NK細胞是機體抗腫瘤、抗感染的重要免疫因素,也參與第Ⅱ型超敏反應和移植物抗宿主反應。
⒈識別靶細胞NK細胞識別靶細胞是非特異性的,這與CTL識別靶細胞機理不同,但確切的機理尚未明了。現已知淋巴細胞功能相關抗原-1(LFA-1)與靶細胞表面的細胞間粘附分子-1(ICAM-1)的作用參與NK細胞的識別過程,抗LFA-1或抗ICAM-1McAb可抑制NK細胞的殺傷活性。此外CD2與LFA-3(CD58)結合以及CD56也可能介導NK細胞與靶細胞的結合。有關白細胞分化抗原和粘附分子分別參見第一章和第二章。
⒉殺傷介質主要有穿孔素、NK細胞毒因子和TNF等。
⑴穿孔素:穿孔素是一種由NK、CTL、LAK等殺傷細胞胞漿顆粒釋放的殺傷靶細胞的介質,有關穿孔素的結構和功能參見本章第二節。從胞漿顆粒中純化的穿孔素在體外能溶解多種腫瘤細胞,抗穿孔素抗體可抑制殺傷活性。IL-2可提高穿孔素基因的轉錄。IL-6可以促進IL-2對穿孔素基因轉錄的誘導作用。絲氨酸酯酶可能有活化穿孔素的作用。
⑵NK細胞毒因子:NK細胞可釋放可溶性NK細胞毒因子(NKcytotoxicfactor,NKCF),靶細胞表面有NKCF受體,NKCF與靶細胞結合後可選擇性殺傷和裂解靶細胞。
⑶TNF:活化的NK細胞可釋放TNF-α和TNF-β(LT),TNF通過①改變靶細胞溶酶體的穩定性,導致多種水解酶外漏;②影響細胞膜磷脂代謝;③改變靶細胞糖代謝使組織中pH降低;④以及活化靶細胞核酸內切酶,降解基因組DNA從而引起程式性細胞死亡等機理殺傷靶細胞。TNF引起細胞死亡過程要明顯慢於穿孔素溶解細胞的作用過程。
表7-12人和小鼠NK敏感和不敏感靶細胞(二)ADCC(antibody-dependentcell-mediatedcytotoxicity)表7-13NK細胞產生的細胞因子。
NK細胞表面具有FcγRⅢA,主要結合人IgG1和IgG3的Fc段(Cγ2、Cγ3功能區),在針對靶細胞特異性IgG抗體的介導下可殺傷相應靶細胞。IL-2和IFN-γ明顯增強NK細胞介導的ADCC作用。以前認為在淋巴細胞中由K細胞介導ADCC,但至今仍未發現K細胞特異的表面標記,也不能證實K細胞是否屬於一個獨立的細胞群,很可能NK是介導ADCC的一個主要淋巴細胞群。具有ADCC功能的細胞群除NK外,還有單核細胞、巨噬細胞、嗜酸性粒細胞和中性粒細胞。
分泌細胞因子
 自然殺傷細胞
自然殺傷細胞此外,NK細胞可抑制PWM體外誘導B細胞的分化及抗體應答,其機理可能通過直接抑制B細胞或抑制輔佐細胞的抗原提呈作用。NK細胞通過自然殺傷和ADCC發揮的細胞毒作用,在機體抗病毒感染、免疫監視中起重要作用。⑴抗病毒感染:NK可選擇性地殺傷病毒感染的靶細胞。由輔佐細胞或NK細胞所產生的IFN可協同NK的抗病毒作用,而對正常細胞有保護作用。另一方面,病毒感染細胞表面的病毒抗原和其它表面分子使得其對NK的殺傷細胞作用變得更加敏感。在體外,NK可溶解皰疹病毒、牛痘病毒、麻疹病毒、腮腺炎病毒、巨細胞病毒和流感病毒感染的靶細胞。體內試驗表明,NK低活性小鼠品系對某些病毒感染更加敏感;注射抑制NK細胞的抗AsialoGM1抗體可加重小鼠流感病毒性肺炎。此外,NK細胞在體外還可殺傷某些細菌、真菌、原蟲等,可能與NK細胞釋放某些殺傷介質有關。⑵NK細胞在免疫監視、殺傷突變的腫瘤細胞可能比T細胞具有更重要的作用。某些疾病如Chediak-Higashi或X性聯淋巴增殖綜合徵患者,由於NK功能缺陷對惡性淋巴細胞增殖疾病特別易感。⑶參與骨髓移植後移植物抗白血病效應(graft-versus-leukemiaeffect,GVL):在體外NK細胞可殺傷某些淋巴樣和髓樣白血病細胞。骨髓移植後數周內,來自供體的NK細胞在PBL中占相當高的比例。此外,在體內NK細胞還可殺傷某些不成熟細胞如骨髓幹細胞、胸腺細胞亞群等。
自然殺傷細胞是一種細胞質中具有大顆粒的細胞,也稱NK細胞。因為其非專一性的細胞毒殺作用而被命名。沒有T細胞B細胞所具的受體,不會進行受體的基因重組。但仍具有一些特殊受體,可以活化或抑制其作用。占循環中淋巴細胞族群的5-10%。和殺死腫瘤細胞有關,可利用分泌穿孔素及腫瘤壞死因子,摧毀目標細胞。
自然殺傷細胞屬於粒狀淋巴細胞,是人體免疫系統的組成部分。它能迅速溶解某些腫瘤細胞,因此開發它的抗癌功能是近年來癌症研究的重點。特別是21世紀初人類開始的生命方舟計畫在開發自然殺傷細胞的抗癌功能方面取得了長足的進步。
NK細胞為什麼不攻擊它的同伴
自然殺傷細胞(黃色)在它們嚴重破壞機體之前識別並殺死癌細胞(粉紅色)或病毒感染的細胞。(圖片來源:科學的眼睛)
人類的免疫系統是非常複雜的,它有著大量不同的細胞具有各種各樣的功能,這確保侵入的微生物如病毒或細菌能夠迅速地使之無害並保持整個機體的健康。
免疫系統還包括自然殺傷細胞(NK細胞),其識別並消除腫瘤或病毒感染的細胞。因此,NK細胞對抗人體自身的應激細胞以防止它們成為一個潛在的危險。然而,這種承擔是有風險性的。其他的免疫細胞——特異性殺傷細胞,也被稱為CD8+T細胞,回響於病毒感染時不斷地繁殖和變得成熟,也可以表現出應激症狀,從而可能終結在NK細胞的名單上。
干擾素偽裝免疫細胞
免疫生物學教授AnnetteOxenius的研究小組現在發現,是什麼阻止nk細胞殺死免疫系統的“來自於其他部門的同事”:健康CD8+T細胞能夠檢測免疫信使物質1型干擾素,1型干擾素通過與這些免疫細胞的特定表面受體結合,從而隱藏它們的應激。換句話說,1型干擾素作為一種偽裝斗篷使得免疫細胞不被NK細胞看見。如果T細胞缺乏1型干擾素的停泊位點,那么它們就會被NK細胞追殺直至滅絕。
使用感染兩種模型病毒的小鼠,研究人員發現,如果動物的CD8+t細胞缺乏這些干擾素的受體,不僅NK細胞消除感染病毒的細胞,而且免疫細胞也被認為採取了行動,從而削弱了抗病毒的免疫反應。
訓練有素的細胞死亡信號
研究人員使用CD8+T細胞沒有任何1型干擾素受體的小鼠探索工作機制是如何運作的,以及缺乏1型干擾素的CD8+T細胞是如何耗盡NK細胞的。如果沒有自然殺手的存在,儘管缺乏干擾素檢測,但T細胞依然會增多,成熟和發育。此外,瑞士蘇黎世聯邦理工學院的免疫生物學家發現,這些無需感測器的T細胞逐漸形成其表面的“識別標籤”,一旦與NK細胞接觸,就會引發NK細胞的殺傷作用。因此,這些“應激標籤”的表達通過干擾素結合以及通過T細胞上的干擾素受體發出信號被抑制。如果由於受體的缺乏而阻止了信號的傳輸,那么細胞會大量表達這些應激分子。
自身免疫性疾病的機制
到目前為止,尚不清楚人類是否具有相同的機制。然而,人類免疫系統用來保護T細胞避免NK細胞攻擊的基本過程很可能是類似的。在一方面,研究人員現在揭示應激T細胞需要保護自己免受NK細胞攻擊的機制。另一方面,這項發現形成了新的假設。例如,可以想到的是,缺乏干擾素受體的T細胞活化顯示出它們為“應激的”,並因此殺死了。自身免疫反應性T細胞的活化過程中可能會出現這樣的情況,例如,它通常發生在不存在高濃度的1型干擾素。Oxenius和她的團隊有很濃厚的興趣將在未來幾年內測試這些令人興奮的假設。
原文摘要:
TypeIInterferonsProtectTCellsagainstNKCellAttackMediatedbytheActivatingReceptorNCR1
JoshCrouse,GregorBedenikovic,MelanieWiesel,MarkIbberson,IoannisXenarios,DorotheeVonLaer,UlrichKalinke,EricVivier,StipanJonjic,AnnetteOxenius
DirecttypeIinterferon(IFN)signalingonTcellsisnecessaryfortheproperexpansion,differentiation,andsurvivalofrespondingTcellsfollowinginfectionwithvirusesprominentlyinducingtypeIIFN.ThereasonsfortheabortiveresponseofTcellslackingthetypeIIFNreceptor(Ifnar1?/?)remainunclear.WereportherethatIfnar1?/?Tcellswerehighlysusceptibletonaturalkiller(NK)cell-mediatedkillinginaperforin-dependentmanner.DepletionofNKcellspriortolymphocyticchoriomeningitisvirus(LCMV)infectioncompletelyrestoredtheearlyexpansionofIfnar1?/?Tcells.Ifnar1?/?Tcellshadelevatedexpressionofnaturalcytotoxicitytriggeringreceptor1(NCR1)ligandsuponinfection,renderingthemtargetsforNCR1mediatedNKcellattack.Thus,directsensingoftypeIIFNsbyTcellsprotectsthemfromNKcellkillingbyregulatingtheexpressionofNCR1ligands,therebyrevealingamechanismbywhichTcellscanevadethepotentcytotoxicactivityofNKcells.
活性測定
 自然殺傷細胞
自然殺傷細胞自然殺傷細胞活性測定
概述
自然殺傷細胞(NK)介導天然免疫應答,它不依賴抗體和補體,即能直接殺傷靶細胞,如腫瘤細胞或受病毒感染的細胞等;此外,尚有免疫調節功能,也參與移植排斥反應和某些自身免疫病的發生髮展。
參考值
51Cr釋放法:自然釋放率<10%~15%;自然殺傷率為47.6%~76.8%;51Cr利用率為6.5%~47.8%。酶釋放法:細胞毒指數為27.5%~52.5%。流式細胞術法為13.8%±5.9%。
臨床意義
NK細胞活性可作為判斷機體抗腫瘤和抗病毒感染的指標之一。在血液系統腫瘤、實體瘤、免疫缺陷病、愛滋病和某些病毒感染患者,NK活性減低;宿主抗移植物反應者,NK活性升高。
其他相關
聖祖德兒童研究醫院的坎帕納博士等人在新一期《血液》雜誌網路版上發表論文說,此前用自然殺傷細胞治療白血病的研究進展不快,主要是因為自然殺傷細胞對白血病細胞不敏感,也難以在實驗室大量培養,而他們在這兩個方面都取得了進展。
研究人員首先使用了含有各種免疫細胞的血樣,將其與經過轉基因處理的K562人類白血病細胞混合培養。這種白血病細胞經轉基因處理後,表面帶有“4-1BBL”和“IL-15”兩種蛋白質。研究人員發現,轉基因白血病細胞能刺激血樣中自然殺傷細胞大量生長,其數量很快達到原先的1萬倍,這使得自然殺傷細胞能提純出來。
此後,研究人員對自然殺傷細胞進行轉基因處理,使其表面生成能識別白血病細胞的受體蛋白。這種受體蛋白能與白血病細胞表面的蛋白質“CD19”結合,促使自然殺傷細胞溶解白血病細胞。
坎帕納等人在論文中說,他們的方法能從少量血樣中培養大量自然殺傷細胞,從而使自然殺傷細胞能實際套用於白血病治療,這尤其適用於接受骨髓移植治療的白血病患者。醫生可以用骨髓捐獻者的血樣大量培養轉基因自然殺傷細胞,然後在移植手術後注射到接受骨髓移植的患者體內,消滅殘餘的白血病細胞。
研究人員說,他們將很快對患有急性淋巴性白血病的兒童進行臨床試驗。如果試驗顯示積極效果,這種方法會成為白血病治療的“利器”之一。

